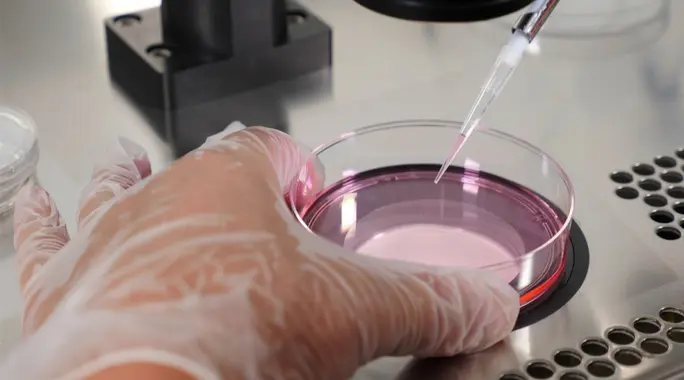

تُعد عملية سحب البويضات خطوة حاسمة في رحلة العديد من النساء نحو تحقيق حلم الأمومة، سواء كان ذلك من خلال التلقيح الصناعي أو بهدف تجميد البويضات للحفاظ على الخصوبة. لضمان أفضل النتائج وتقليل أي مخاطر محتملة، يتطلب هذا الإجراء تحضيرًا دقيقًا والتزامًا ببعض التعليمات قبل عملية سحب البويضات. يساعدكِ هذا الدليل على فهم كل ما تحتاجين معرفته والاستعداد بثقة لهذه الخطوة المحورية.
- لماذا تُجرى عملية سحب البويضات؟
- تعليمات أساسية قبل سحب البويضات
- كيف تتم عملية سحب البويضات؟
- ماذا بعد عملية سحب البويضات؟
- الخلاصة
لماذا تُجرى عملية سحب البويضات؟
تُعد عملية سحب البويضات إجراءً أساسيًا في طب الإنجاب، وتُجرى لعدة أسباب رئيسية تعتمد على الأهداف العلاجية للمرأة.
التلقيح الصناعي وأطفال الأنابيب
تعتبر هذه العملية جزءًا لا يتجزأ من علاجات الإخصاب المساعد مثل التلقيح الاصطناعي (IVF). يقوم الأطباء بسحب البويضات الناضجة لتخصيبها في المختبر بواسطة الحيوانات المنوية، ثم يتم إعادة زرع الأجنة الناتجة في رحم المرأة لإكمال عملية الحمل.
تجميد البويضات للحفاظ على الخصوبة
تلجأ العديد من النساء إلى تجميد البويضات كخيار استباقي للحفاظ على خصوبتهن. يسمح هذا الإجراء للنساء بتأجيل الحمل لأسباب طبية أو شخصية، مع ضمان توافر بويضات سليمة للاستخدام في المستقبل.
تعليمات أساسية قبل سحب البويضات
يضمن الالتزام الدقيق بالتعليمات قبل عملية سحب البويضات الحصول على أكبر عدد من البويضات الناضجة والجاهزة للإخصاب أو التجميد، ويقلل من فرص حدوث المضاعفات.
التحضير الدوائي والهرموني
تلتزم المرأة عادةً بتناول أدوية محفزة للإخصاب لمدة أسبوعين تقريبًا قبل العملية. تهدف هذه الأدوية إلى رفع مستويات الهرمونات المسؤولة عن إنتاج بويضات ناضجة متعددة. بالإضافة إلى ذلك، تُعطى حقنة من هرمون موجهة الغدد التناسلية المشيمائية البشرية (HCG) في توقيت دقيق، حيث يساعد هذا الهرمون على إكمال نضوج البويضات وتحريرها من الحويصلات.
تجنب أدوية معينة
يجب عليكِ تجنب تناول بعض الأدوية قبل العملية، مثل المسكنات التي تحتوي على الأيبوبروفين (Ibuprofen)، والنابروكسين (Naproxen)، والأسيتامينوفين (Acetaminophen)، ما لم يوجهكِ طبيبكِ بخلاف ذلك. استشيري طبيبكِ دائمًا بشأن أي أدوية تتناولينها.
الصيام قبل الإجراء
من الضروري الامتناع عن تناول الطعام والمشروبات لمدة تتراوح بين 8 إلى 10 ساعات قبل موعد سحب البويضات. يُجرى هذا الإجراء تحت التخدير، ووجود أي محتويات في المعدة يمكن أن يتعارض مع عملية التخدير ويسبب مضاعفات خطيرة.
الاستعداد الشخصي والراحة
ارتدي ملابس فضفاضة ومريحة عند التوجه إلى المستشفى لتسهيل عملية التغيير إلى مريول غرفة العمليات. كما يجب إزالة أي مجوهرات، والحرص على عدم وضع طلاء أظافر، أو استخدام كريمات وعطور قد تعيق عمل الفريق الطبي.
إجراءات ما قبل الدخول للمستشفى
ننصحكِ بطلب المساعدة من أحد المرافقين ليرافقكِ قبل العملية ولمدة 24 ساعة بعدها، لتسهيل عودتكِ إلى المنزل والاهتمام بكِ. جهزي أغراضكِ الشخصية الضرورية في حقيبة صغيرة قبل دخول المستشفى. قبل العملية مباشرة، تأكدي من إفراغ مثانتكِ تمامًا.
كيف تتم عملية سحب البويضات؟
تستغرق عملية سحب البويضات عادةً من 15 إلى 20 دقيقة. يقوم الطبيب بإدخال إبرة رفيعة عبر المهبل، مستخدمًا الموجات فوق الصوتية لتوجيهها بدقة إلى كل حويصلة تحتوي على البويضات. تُسحب البويضات الناضجة بعناية وتُجمع في أنابيب اختبار خاصة. تُجرى العملية تحت التخدير لتجنب أي إزعاج أو ألم للمريضة، مما يضمن راحتها طوال الإجراء.
ماذا بعد عملية سحب البويضات؟
بعد انتهاء العملية، يتم نقل المريضة إلى غرفة التعافي. يستغرق الاستيقاظ من التخدير بضع دقائق إلى عدة ساعات للتخلص من آثاره بشكل كامل.
التعافي الفوري بعد الإجراء
قد تشعرين ببعض الغثيان، وقد يصف لكِ الطبيب أدوية وريدية للتخفيف منه. من الطبيعي أيضًا الشعور بتقلصات خفيفة في منطقة البطن أو بعض الألم، وسيصف لكِ الطبيب مسكنات للتعامل مع ذلك.
نصائح للتعافي السريع في المنزل
- ابدئي بتناول الطعام الصحي والخفيف تدريجيًا.
- احصلي على قسط وافر من الراحة والاسترخاء.
- تجنبي الأنشطة البدنية المجهدة تمامًا.
- راجعي طبيبكِ قبل تناول أي دواء جديد.
- لا تقودي السيارة لمدة 24 ساعة على الأقل بعد العملية.
- التزمي بالعلاج الهرموني الذي يصفه لكِ الطبيب بعد العملية لدعم بطانة الرحم.
متى يجب استشارة الطبيب؟
من المهم مراقبة حالتكِ بعد العملية والاتصال بطبيبكِ فورًا في حال ظهور أي من الأعراض التالية:
- عدم استقرار المؤشرات الحيوية.
- نزيف مهبلي غير طبيعي.
- غثيان مستمر أو عدم القدرة على تناول الطعام دون تقيؤ.
- عدم التبول خلال 8-10 ساعات بعد العملية.
- ألم مستمر لا يستجيب للمسكنات.
- ارتفاع في درجة حرارة الجسم.
الخلاصة
تُعد عملية سحب البويضات خطوة محورية في تحقيق حلم الأمومة، والالتزام بالتعليمات والإرشادات قبل وبعد الإجراء أمر بالغ الأهمية لضمان سلامتكِ وتحقيق أفضل النتائج الممكنة. باتباع هذا الدليل، يمكنكِ الاستعداد بثقة لهذه التجربة، والمضي قدمًا في رحلتكِ نحو الأمومة بخطى ثابتة ومدروسة.